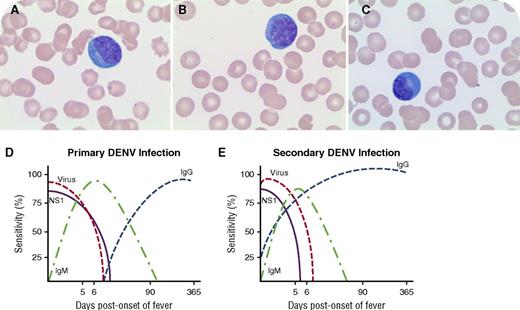
A 36-year-old man presented with fever, myalgia, and fatigue after a trip to India. Laboratory studies revealed a white blood cell count of 2.8 × 109/L, hematocrit of 40.1%, platelet count of 18 × 109/L, abnormal liver function tests, elevated fibrin degradation products, and elevated D-dimer levels. Serologic tests for Epstein-Barr virus and cytomegalovirus were consistent with past infection and were negative for chikungunya virus, HIV, and hepatitis B virus. A peripheral blood smear was negative for parasites; however, increased atypical plasmacytoid lymphocytes (28%) were seen (panels A-C; original magnification ×100, Wright-Giemsa stain). A serologic test demonstrated increased dengue virus immunoglobulin G (IgG) titers at 15.08 IV (normal, ≤1.64 IV) while dengue virus IgM titer was normal at 1.41 IV (normal, ≤1.64 IV), consistent with secondary infection. Supportive treatment resulted in full resolution of symptoms, platelet recovery to 97 × 109/L, and disappearance of plasmacytoid lymphocytes. / Atypical plasmacytoid lymphocytes can be seen in dengue virus infection in addition to other conditions such as serum sickness, hyperimmunization, and rubella. Although typically high IgM and IgG levels are detected in primary infection (panel D), IgM can be significantly lower or undetectable in secondary infection (panel E) (panels D-E are adapted from https://www.cdc.gov/dengue/clinicallab/laboratory.html). Ideally, further confirmation is recommended using polymerase chain reaction, viral culture, or IgM/IgG seroconversion in paired sera. The presence of atypical plasmacytoid lymphocytes in a proper clinical context should alert the physician toward a possible diagnosis of dengue virus infection and necessitates further testing.

A 36-year-old man presented with fever, myalgia, and fatigue after a trip to India. Laboratory studies revealed a white blood cell count of 2.8 × 109/L, hematocrit of 40.1%, platelet count of 18 × 109/L, abnormal liver function tests, elevated fibrin degradation products, and elevated D-dimer levels. Serologic tests for Epstein-Barr virus and cytomegalovirus were consistent with past infection and were negative for chikungunya virus, HIV, and hepatitis B virus. A peripheral blood smear was negative for parasites; however, increased atypical plasmacytoid lymphocytes (28%) were seen (panels A-C; original magnification ×100, Wright-Giemsa stain). A serologic test demonstrated increased dengue virus immunoglobulin G (IgG) titers at 15.08 IV (normal, ≤1.64 IV) while dengue virus IgM titer was normal at 1.41 IV (normal, ≤1.64 IV), consistent with secondary infection. Supportive treatment resulted in full resolution of symptoms, platelet recovery to 97 × 109/L, and disappearance of plasmacytoid lymphocytes.
Atypical plasmacytoid lymphocytes can be seen in dengue virus infection in addition to other conditions such as serum sickness, hyperimmunization, and rubella. Although typically high IgM and IgG levels are detected in primary infection (panel D), IgM can be significantly lower or undetectable in secondary infection (panel E) (panels D-E are adapted from https://www.cdc.gov/dengue/clinicallab/laboratory.html). Ideally, further confirmation is recommended using polymerase chain reaction, viral culture, or IgM/IgG seroconversion in paired sera. The presence of atypical plasmacytoid lymphocytes in a proper clinical context should alert the physician toward a possible diagnosis of dengue virus infection and necessitates further testing.
A 36-year-old man presented with fever, myalgia, and fatigue after a trip to India. Laboratory studies revealed a white blood cell count of 2.8 × 109/L, hematocrit of 40.1%, platelet count of 18 × 109/L, abnormal liver function tests, elevated fibrin degradation products, and elevated D-dimer levels. Serologic tests for Epstein-Barr virus and cytomegalovirus were consistent with past infection and were negative for chikungunya virus, HIV, and hepatitis B virus. A peripheral blood smear was negative for parasites; however, increased atypical plasmacytoid lymphocytes (28%) were seen (panels A-C; original magnification ×100, Wright-Giemsa stain). A serologic test demonstrated increased dengue virus immunoglobulin G (IgG) titers at 15.08 IV (normal, ≤1.64 IV) while dengue virus IgM titer was normal at 1.41 IV (normal, ≤1.64 IV), consistent with secondary infection. Supportive treatment resulted in full resolution of symptoms, platelet recovery to 97 × 109/L, and disappearance of plasmacytoid lymphocytes.
Atypical plasmacytoid lymphocytes can be seen in dengue virus infection in addition to other conditions such as serum sickness, hyperimmunization, and rubella. Although typically high IgM and IgG levels are detected in primary infection (panel D), IgM can be significantly lower or undetectable in secondary infection (panel E) (panels D-E are adapted from https://www.cdc.gov/dengue/clinicallab/laboratory.html). Ideally, further confirmation is recommended using polymerase chain reaction, viral culture, or IgM/IgG seroconversion in paired sera. The presence of atypical plasmacytoid lymphocytes in a proper clinical context should alert the physician toward a possible diagnosis of dengue virus infection and necessitates further testing.
For additional images, visit the ASH IMAGE BANK, a reference and teaching tool that is continually updated with new atlas and case study images. For more information visit http://imagebank.hematology.org.